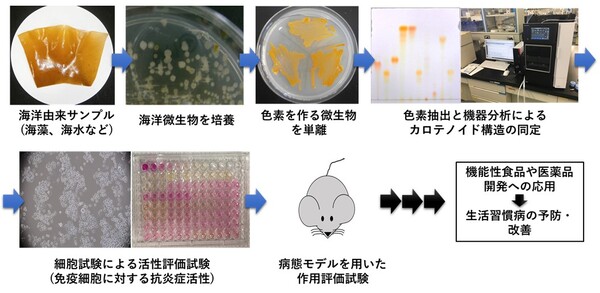
生活習慣病の予防に繋がる健康機能性カロテノイドを海洋から発掘する

マイストア
変更
お店で受け取る
(送料無料)
配送する
納期目安:
2026.02.23 4:16頃のお届け予定です。
決済方法が、クレジット、代金引換の場合に限ります。その他の決済方法の場合はこちらをご確認ください。
※土・日・祝日の注文の場合や在庫状況によって、商品のお届けにお時間をいただく場合がございます。
カロテノイド ―その多様性と生理活性― 書籍紹介> カロテノイド(高市真一 編集)【生物学】の詳細情報
書籍紹介> カロテノイド(高市真一 編集)【生物学】。生活習慣病の予防に繋がる健康機能性カロテノイドを海洋から発掘する。fig_pg010_02_jp.jpg。「カロテノイド ―その多様性と生理活性―」高市 真一 / 三室 守 / 富田 純史定価: ¥ 4000カバーにスレやヨレがありますが、本体はとてもキレイです。大切に読んでいただける方にお譲りしたいです。。エッセンシャルオイル デスクレファレンス 第6版。パラパラと見た程度で、ほとんど読んでいません。【裁断済】 消化器内科 ただいま回診中 the G 2冊セット。GPのためのアライナーシミュレーションガイド ⚠️裁断済み。よろしくお願いいたします。THE内科専門医問題集.1.2.3
ベストセラーランキングです
近くの売り場の商品
カスタマーレビュー
オススメ度 4.9点
現在、4139件のレビューが投稿されています。